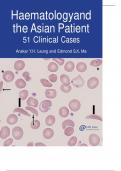

Top Scorer
Helping all Students fulfill their educational, career and personal goals.
- 454
- 0
- 21
Community
- Seguidores
- Siguiendo
24 Comentarios recibidos
480 artículos

Applied Probability and Stochastic Processes, Second Edition (Solutions, Instructor Solution Manual)
Complete A+ Guide to: Applied Probability and Stochastic Processes, Second Edition (Solutions, Instructor Solution Manual)
- Book
- Examen
- • 169 páginas •
Complete A+ Guide to: Applied Probability and Stochastic Processes, Second Edition (Solutions, Instructor Solution Manual)

A First Course on Symmetry, Special Relativity and Quantum Mechanics: The Foundations of Physics, First Edition (Instructor Solution Manual, Solutions)
A First Course on Symmetry, Special Relativity and Quantum Mechanics: The Foundations of Physics, First Edition (Instructor Solution Manual, Solutions) A First Course on Symmetry, Special Relativity and Quantum Mechanics: The Foundations of Physics (Undergraduate Lecture Notes in Physics) 1st ed. 2024 Edition by Gabor Kunstatter (Author), Saurya Das
- Book
- Examen
- • 98 páginas •
A First Course on Symmetry, Special Relativity and Quantum Mechanics: The Foundations of Physics, First Edition (Instructor Solution Manual, Solutions) A First Course on Symmetry, Special Relativity and Quantum Mechanics: The Foundations of Physics (Undergraduate Lecture Notes in Physics) 1st ed. 2024 Edition by Gabor Kunstatter (Author), Saurya Das

Student Solutions Manual for Stewart's Single Variable Calculus: Early Transcendentals, 8th (James Stewart Calculus) 8th Edition
Student Solutions Manual for Stewart's Single Variable Calculus: Early Transcendentals, 8th (James Stewart Calculus) 8th Edition ontains fully worked-out solutions to all of the odd-numbered exercises in the text, giving students a way to check their answers and ensure that they took the correct steps to arrive at an answer.
- Book
- Examen
- • 571 páginas •
Student Solutions Manual for Stewart's Single Variable Calculus: Early Transcendentals, 8th (James Stewart Calculus) 8th Edition ontains fully worked-out solutions to all of the odd-numbered exercises in the text, giving students a way to check their answers and ensure that they took the correct steps to arrive at an answer.

Complete Classical Mechanics Student Solutions Manual First Edition by John R. Taylor
restates odd-numbered problems from Taylor's superb CLASSICAL MECHANICS, and then provides detailed solutions.
- Book
- Otro
- • 224 páginas •
restates odd-numbered problems from Taylor's superb CLASSICAL MECHANICS, and then provides detailed solutions.

Loss Models: From Data to Decisions, 5e Student Solutions Manual (complete course)
A guide that provides in-depth coverage of modeling techniques used throughout many branches of actuarial science, revised and updated Now in its fifth edition, Loss Models: From Data to Decisions puts the focus on material tested in the Society of Actuaries (SOA) newly revised Exams STAM (Short-Term Actuarial Mathematics) and LTAM (Long-Term Actuarial Mathematics). Updated to reflect these exam changes, this vital resource offers actuaries, and those aspiring to the profession, a practical appr...
- Book
- Otro
- • 363 páginas •
A guide that provides in-depth coverage of modeling techniques used throughout many branches of actuarial science, revised and updated Now in its fifth edition, Loss Models: From Data to Decisions puts the focus on material tested in the Society of Actuaries (SOA) newly revised Exams STAM (Short-Term Actuarial Mathematics) and LTAM (Long-Term Actuarial Mathematics). Updated to reflect these exam changes, this vital resource offers actuaries, and those aspiring to the profession, a practical appr...
Case Haematology and the Asian Patient 51 Clinical Case Hematology and the Asian Patient (COMPLETE 2024)
Case Haematology and the Asian Patient 51 Clinical Case Hematology and the Asian Patient
- Book
- Caso
- • 243 páginas •
Case Haematology and the Asian Patient 51 Clinical Case Hematology and the Asian Patient

Complete Answered: Contemporary Entrepreneurship: Global Perspectives and Cases (Routledge Studies in Entrepreneurship and Small Business)
Contemporary Entrepreneurship: Global Perspectives and Cases (Routledge Studies in Entrepreneurship and Small Business)
- Book
- Caso
- • 206 páginas •
Contemporary Entrepreneurship: Global Perspectives and Cases (Routledge Studies in Entrepreneurship and Small Business)

Case Paediatric Cases in Coloured Skin Paediatric Cases in Coloured Skin
Dermatology is a visual discipline where observation to detail is key to accurate diagnosis, especially in children. This book for clinicians provides a clear and easy guide to identify skin diseases in children with coloured skin. It discusses more than 200 skin problems with over 300 colour Illustrations following a logical organisation with picture-based Q&A at the end. It features skin problems specific to children such as haemangiomas, congenital naevi, neurocutaneous syndromes, napkin rash...
- Book
- Caso
- • 180 páginas •
Dermatology is a visual discipline where observation to detail is key to accurate diagnosis, especially in children. This book for clinicians provides a clear and easy guide to identify skin diseases in children with coloured skin. It discusses more than 200 skin problems with over 300 colour Illustrations following a logical organisation with picture-based Q&A at the end. It features skin problems specific to children such as haemangiomas, congenital naevi, neurocutaneous syndromes, napkin rash...

(Complete) Cases on Applying Knowledge Economy Principles for Economic Growth in Developing Nations (Advances in Finance, Accounting, and Economics)
Cases on Applying Knowledge Economy Principles for Economic Growth in Developing Nations (Advances in Finance, Accounting, and Economics) ANSWERED.
- Book
- Caso
- • 358 páginas •
Cases on Applying Knowledge Economy Principles for Economic Growth in Developing Nations (Advances in Finance, Accounting, and Economics) ANSWERED.

Complete SOLUTIONS MANUAL Introduction to Finite Elements in Engineering (Fifth edition)
Complete SOLUTIONS MANUAL Introduction to Finite Elements in Engineering (Fifth edition)
- Book
- Otro
- • 0 páginas •
Complete SOLUTIONS MANUAL Introduction to Finite Elements in Engineering (Fifth edition)

The Finite Element Method in Engineering, 6th Ed Solution Manual Complete.
COUN 6723 | Multicultural Counseling Week 3 Quiz | Answered.
NCLEX-RN Examination 9th Edition Complete Saunders Comprehensive Review ; PDF file.
Updated NIH Stroke Scale – All Test Groups A-F (patients 1-6) Answer key Updated Summer 2024.
Nuclear Energy, Eighth Edition Solutions to Exercises Raymond L. Murray/ Complete Solved Questions to all chapters, A+ Graded.